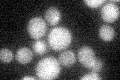
YIL122W
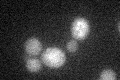
YIL122W

View description
Putative transcriptional activator that promotes recovery from pheromone induced arrest; inhibits both alpha-factor induced G1 arrest and repression of CLN1 and CLN2 via SCB/MCB promoter elements; potential Cdc28p substrate; SBF regulated
Localization:
Intensity:
Fold change:
Significance:
-
C’ GFP library in SD
cytosol18.85 -
N' NOP1pr-GFP in SD

nucleus53.1944 -
N' TEF2pr-mCherry in SD

nucleus0 -
N' NATIVEpr-GFP in SD

punctate,nucleus22.2297 -
N' TEF2pr-VC and Cyto-VN in SD

#N/A0 -
C’ GFP library in SD+DTT
cytosol14.530.77No -
C’ GFP library in SD+H2O2

cytosol17.960.95No -
C’ GFP library in Starvation Media

cytosol21.191.12No -
C’ GFP library on the background of Pup2-DaMP

cytosol -
C’ GFP library on the background of CCT mutant

cytosol17.32930.918918No
